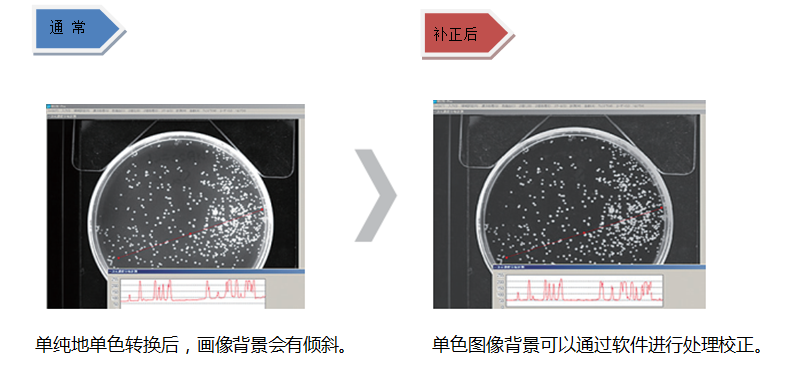
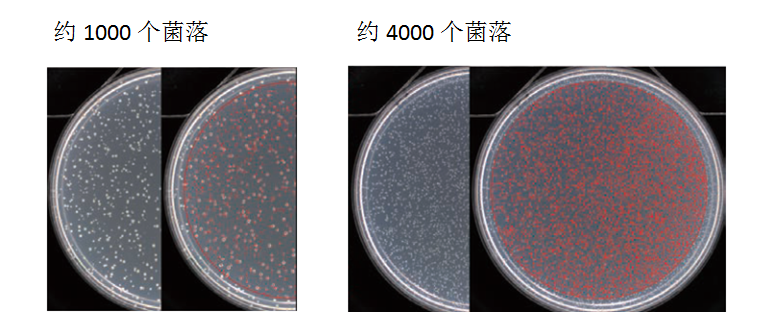
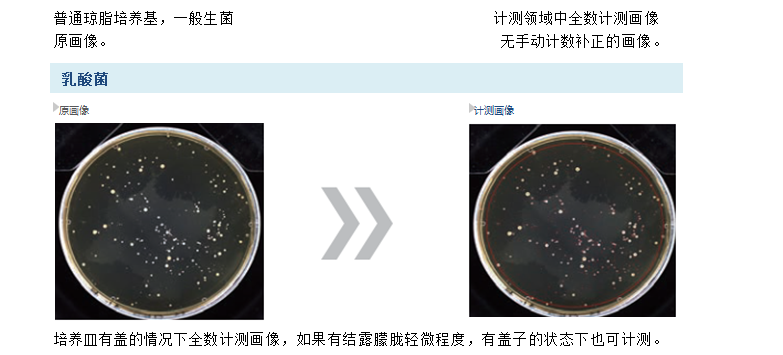
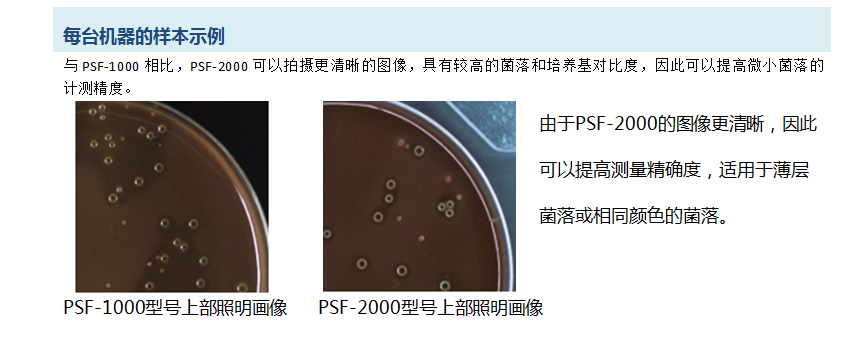

原理(lǐ):高(gāo)速圖像處理(lǐ)使得(de)操作(zuò)更加快(kuài)捷。沒有(yǒu)疲勞,它可(kě)以讓一(yī)個(εgè)人(rén)完成更多(duō)的(de)樣本計(jì)測。

原理(lǐ):每個(gè)菌落的(de)面積計(jì)算(suàn)可(kě)以單獨測量指定的(de)直徑。隻要(yào)培養基厚度固定,它就(jiù)能(né™ng)夠通(tōng)過固定的(de)二值化(huà)系數(shù)隻測量指定的(de)菌落。

原理(lǐ):在自(zì)動測量時(shí),可(kě)以從(cóng)測量對(duì)象中自(zì)動排除大(dà)的(de)菌落。可(kě)測量的(de)區(qū)域可(kě)自(zì)動計(j<ì)算(suàn),并可(kě)實現(xiàn)精确的(de)CFU轉換。

不(bù)同數(shù)量菌落的(de)計(jì)數(shù)結果精度

「自(zì)動菌落計(jì)數(shù)儀」特點
---各種菌落數(shù)量可(kě)以實現(xiàn)高(gāo)精度計(jì)數(shù)。

測量結果可(kě)以顯示或傳輸到(dào)Excel文(wén)件(jiàn)
在默認設置下(xià),Petri Dish No,菌落數(shù)量和(hé)測量區(qū)域将顯示在軟件(jiàn)上(shàng)。測量結果可(kě)以轉換為(wèi)Excel工(gōng)作(zuò)表或CSV文(wén)件(jiàn)。



「自(zì)動菌落計(jì)數(shù)儀」
--标準軟件(jiàn)可(kě)以管理(lǐ)圓形、矩形和(hé)螺旋形等各種樣本。



●軟件(jiàn)

全球頂級「自(zì)動計(jì)測菌落計(jì)數(shù)儀」--擁有(yǒu)豐富的(de)計(jì)測事(shì)例。

選配件(jiàn)
抑菌圈計(jì)測軟件(jiàn)


國(guó)初科(kē)技(jì)(廈門(mén))有(yǒu)限公司
中國(guó)·福建·廈門(mén)
電(diàn)話(huà):0592-6518670
傳真:0592-6514970
郵箱:info@guochukeji.com
網址:www.guochukeji.com